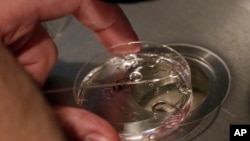
Ahli embryologi Rick Slifkin memperlihatkan teknik pembuahan dari donor sperma dan dua sel telur di sebuah klinik di New York. (Foto: Dok)

Inggris telah membuka Bank Sperma Nasional untuk memenuhi semakin banyaknya permintaan atas donor.
Bank sperma tersebut berbasis di Rumah Sakit Perempuan Birmingham, 185 kilometer dari ibukota London.
Pihak berwenang mengatakan Kamis (30/10) bahwa bank itu dirancang untuk membantu perempuan lajang, pria dengan masalah kesuburan dan pasangan sesama jenis untuk membangun keluarga.
Bank tersebut didirikan untuk mengatasi kekurangan donor sperma di saat jumlah pasien yang mencari donasi sperma meningkat.
Bank Sperma Nasional akan dikelola oleh lembaga National Gamete Donation Trust bekerja sama dengan rumah sakit tersebut. Bank tersebut dikatakan akan mengurangi jumlah pasien yang "menempatkan dirinya dalam risiko" dengan menggunakan layanan-layanan yang tidak teregulasi. (AP)